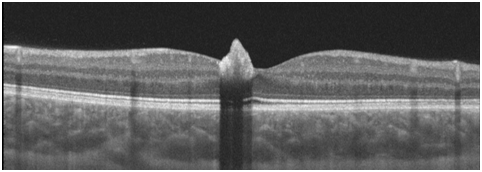

Advances in
eISSN: 2377-4290


Case Report Volume 9 Issue 5
1Department of Ophthalmology, Sant’Orsola Malpighi Hospital, Italy
2Department of Ophthalmology, University of Bologna, Italy
Correspondence: A Gurreri, Department of Ophthalmology, University of Bologna, Italy
Received: September 19, 2019 | Published: September 24, 2019
Citation: Pazzaglia, Gurreri A. Multimodal imaging in congenital simple hamartoma of retinal pigment epithelium (CSHRPE): optical coherence tomography (OCT), autofluorescence and oct angiography, a review of the literature and case presentation. Adv Ophthalmol Vis Syst. 2019;9(5):113-116. DOI: 10.15406/aovs.2019.09.00359
Purpose: To report a case of congenital simple Hamartoma of retinal pigment epithelium (CSHRPE) with avulsion of RPE without visual impairment.
Methods: A 11-years-old Caucasian male presented with full visual acuity in both eyes, and was made diagnosis of CSHRPE after a complete ophthalmological examination. Was also performed: fundus photographs, spectral domain optical coherence tomography (SD-OCT), fundus autofluorescence (FAF) and OCT angiography (OCT-A).
Results: He presented with full visual acuity in both eyes; fundus examination showed a small, darkly pigmented, well-circumscribed lesion involving the central fovea in the right eye.
Conclusion:This case shows a rare complication such as avulsion can be still associated with high visual acuity.
Despite CSHRPE was storically defined as congenital pigment epithelial adenomas or primary pigment epithelial hyperplasia without vascular or glial components; the new sophisticated imaging techniques show the coexistence of a vascular and glial involvement. So CSHRPE can be defined as isolated RPE Hamartoma for the prevalence of the epithelial component, but this is not the only component. These new sofisticated techniques, especially OCT and OCT-A, should take us to consider Retinal Hamartomas like a broad spectrum.
SD-OCT, spectral domain optical coherence tomography; FAF, fundus autofluorescence; OCT-A, OCT angiography; CSHRPE, congenital simple hamartoma of retinal pigment epithelium; RPEH, retinal pigment epithelial hamartoma
According to Gass Retinal Pigment Epithelial Hamartoma (RPEH) is a presumed congenital pigment epithelial adenomas or primary pigment epithelial hyperplasia.1 RPEH is a non-hereditary benign retinal tumour of unknown aetiology, possibly due to translocation between the short arms of chromosomes 11 and 18, like Combined Hamartoma of the Retina and Retinal Pigment Epithelium.2 Congenital simple Hamartoma of Retinal Pigment Epithelium (CSHRPE) was first recognized in 1981 by Laqua3 and later characterized and named in 1989 by Gass, who reported ten cases.1 In 2003, Shields documented the largest subsequent case series, consisting of five patients.4 CSHRPE is a rare intraocular finding that is described as a unilateral, focal, nodular, jet black lesion. That frequently occur at or near the macula, no known association with changes in the surrounding neurosensory retina, RPE or choroid, nor have they been related with exudation or hemorrhage . Usually, involves the full thickness of the retina through the I.L.M. (Internal Limiting Membrane) with an umbrella shaped in the inner retinal surface.1 The patients are asymptomatic, and usually have normal visual acuity. For this reason though these lesions are congenital, they often are not identified until adulthood. Although, sometimes children may develop amblyopia and strabismus due to macular involvement.
CSHRPE ordinarily shows no changes in 15 years follow-up
A 11-years-old Caucasian male presented with full visual acuity in both eyes (20/20). The patient underwent complete ophthalmic examination, spectral domain opticalcoherence tomography (SD-OCT), multicolour imaging, fundus autofluorescence (FAF) and OCT angiography (OCT-A). Fundus slit-lamp examination revealed a small, darkly pigmented, well-circumscribed lesion involving the central fovea in the right eye (Figure 1). With no clinical evidence of vascular/glial abnormalities. No abnormalities was found in the fellow eye. The FAF showed pronounced, homogeneus hypo-autofluorescence of the lesion (Figure 2).
The OCT demonstrated that the lesion’s surface was hyper-reflective with distinct borders and significant underlying shadowing, which prevents a detailed evaluation of outer retina/ choriocapillaris. No Inner/Outer retinal alterations of adjacent retina and fluid are visible at OCT images (Figure 3). A star shaped fovea and a possible minimal vitreo-macular traction is visible in the reconstruction of the macular surface of the right eye. (Figure 4). Clearly visible if compared to normal foveal excavation of the fellow eye (Figure 5). In the OCT-A we observed a mild intralesional vascularization, not visible by SD-OCT scans or slit lamp examination, both in the superficial and deep capillary plexus (Figure 6). Indeed, foveal hypo-reflectance for masking effect in Outer retina and Choriocapillaris layers at OCT-A was recorded (Figure 7A&B).

Figure 1 Small, darkly pigmented, well-circumscribed lesion involving the central fovea No clinical evidence of vascular/glial abnormalities.
Figure 3 OCT Lesion’s surface was hyper-reflective and demonstrated distinct borders Significant underlying shadowing, which prevents a detailed evaluation of outer retina/ choriocapillaris.
Despite CSHRPE was storically defined as congenital pigment epithelial adenomas or primary pigment epithelial hyperplasia without vascular or glial components; the new sophisticated imaging techniques show the coexistence of a minimal vascular and glial involvement. Recently, reviews have been made to classify the Combined Hamartomas,5 but about CSHRPE have practically remained at the Gass classification of 1989. Reviewing the literature, SD-OCT of CSHRPE shows a mild dome-shape elevation of the inner retinal surface with abrupt, absolute shadowing of the deeper retinal tissue.6,7 As we already said in literature, CSHRPE remains stable over time, usually without developing complications.1 Although rarely complications may have been described. Zografos described some rare complications: avulsion, macular hole and vitreo-macular traction.8,9 Gliosis of the surface or signs of vitreous-macular traction strongly evoke forms of transition to Combined Hamartomas.10
The avulsion is a specific complication of CSHRPE. In literature, two pathogenetic hypothesis have been formulated. The first hypothesis is that a single or a group of RPE cells migrated to the retinal surface during embryogenesis and then proliferated into an hamartomatous lesion that did not involve the full retinal thickness . The second possibility comprises RPE cell migration, due to traction created by this lesion.9 Our case presents an avulsion without vitreo-macular traction. The avulsion was clearly visible at SD-OCT (Figure 3). In our case the SD-OCT scans did not show signs of vitreous-macular tractions. Conversely, Barns et al decribed a case of CSHRPE with avulsion, severe vitreo-macular traction and tractional oedema.9 Despite there was no signs of vitreomacular traction at SD-OCT, in the reconstruction of the macular surface of the right eye there was star shaped fovea and a minimal gliosis with a Internal Limiting Membrane (ILM) minimum involvement (Figure 4). Furthermore, OCT-A showed a mild intralesional vascularization not visible by SD-OCT scans or slit lamp examination, both in the superficial and deep capillary plexus (Figure 6A&B).
In Gass’classification of Retinal Pigment Epithelial Hamartoma three different stages could be identified:
According to this classification this case as an isolated hamartomas, belongs to stage 1, since signs of glial or vascular involvement should not coexist neither ophthalmoscopically nor SD-OCT. Actually, the OCT-A allows to highlight a minimal vascular component that cannot be visualized ophthalmoscopically and to SD-OCT. OCT-A reveals one of the other components involved and it allows us to longitudinly predict the expressivity of complcations. In this case the OCT-A assumes a relevance even prognostic. Therefore, the coexistence in minimal form, of vascular and glial involvement demostrated by these new sofisticated techniques should take us to consider Hamartomas like a broad spectrum. So CSHRPE could be defined as isolated RPE Hamartoma for the prevalence of the epithelial component, but the epithelial componentent is not exlusive.
None.
Nill.
None.
Author declares that there is no conflict of interest.

©2019 Pazzaglia,, et al. This is an open access article distributed under the terms of the, which permits unrestricted use, distribution, and build upon your work non-commercially.